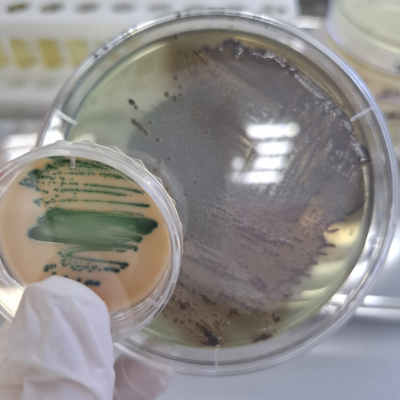
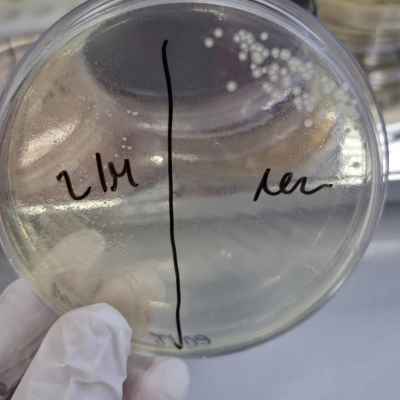

В отдел бактериологии, паразитологии и питательных сред Краснодарской испытательной лаборатории ФГБУ «ВНИИЗЖ» доставлен труп суриката в возрасте 4 лет, животное не вакцинировано, проживало в доме с владельцами.
Сурикат – это небольшое млекопитающее из семейства мангустовых (Herpestidae), известное своим социальным образом жизни и характерной стоячей позой на задних лапах, обитает в пустынях и полупустынях южной Африки (ЮАР, Намибия, Ботсвана, Ангола). Питается животное в основном насекомыми, пауками, скорпионами, мелкими позвоночными, яйцами и иногда растениями, устойчиво к укусам некоторых змей и скорпионов.
В помете обычно несколько детёнышей. Продолжительность жизни в дикой природе 6-8 лет, в неволе – дольше.
При патологоанатомическом исследовании суриката установлены: увеличение миокарда, кровенаполненность внутренних органов, отёк легких, фибринозные наложения на поверхности печени, увеличение селезёнки, кровоизлияния на слизистой оболочке кишечника. Просвет кишечника плотно заполнен непереварившимися частями корма – фрагментами тела сверчков, непереваренными остатками растительной пищи. Из опроса владельцев установлено, что животное не болело и погибло вскоре после употребления новой партии сверчков – обычной пищи этих животных в неволе.
При бактериологическом исследовании доставленного материала из паренхиматозных органов, крови, головного и костного мозга на питательных средах с последующей дифференциальной диагностикой, а также постановкой биологической пробы на лабораторных животных, выделены возбудители смешанной кишечной инфекции: культуры Citrobacter freundii, Enterococcus faecalis, Proteus mirabilis и Staphylococcus aureus.
В данном случае сверчки могли стать причиной инфекции у суриката, т.к. могут являться переносчиками сальмонелл, других патогенных бактерий, некоторых паразитов и реже вирусов. У маленького по размеру животного быстро развивается сепсис или тяжёлая диарея с обезвоживанием.
У суриката могут наблюдаться такие симптомы, как:
Что делать, если обнаружили данные симптомы, либо есть ещё животные?
Установить причину помогут:
Меры профилактики заболеваний, вызванных некачественным кормом у домашних сурикатов:
Правильно и своевременно поставленный диагноз позволит вам грамотно провести лечение с учётом чувствительности выделенных культур к антибактериальным препаратам, в том числе при необходимости к бактериофагам, получить лечебный эффект. Для прижизненной диагностики в качестве биоматериала при септических инфекциях можно сдать кровь, также при других формах инфекций - фекалии, мочу, смывы и соскобы от животного для проведения бактериологического, паразитологического исследования, а также на диагностику с помощью ПЦР при наличии соответствующих тест-систем в ветеринарную лабораторию; при кишечных инфекциях не менее 1 грамма фекалий в стерильной посуде, при инфекциях мочевыделительной системы – асептически отобранную пробу мочи, при инфекциях слизистых оболочек и кожи – смывы и соскобы с необходимых мест.
Врачи отдела бактериологии, паразитологии и питательных сред Краснодарской испытательной лаборатории ФГБУ «ВНИИЗЖ» имеют обширный опыт в диагностике условно-патогенной и патогенной микрофлоры всех систем организма животных при помощи классических бактериологических методов, а также импортных и отечественных тест-систем.